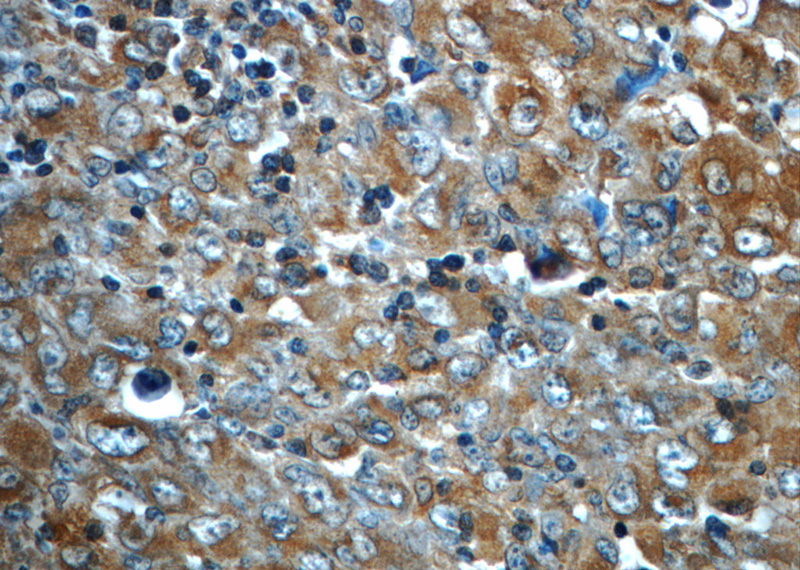
Immunohistochemistry of paraffin-embedded human lymphoma slide using (ALK,CD246 Antibody) at dilution of 1:50

-
Product Name
ALK,CD246 antibody
- Documents
-
Description
ALK,CD246 Mouse Monoclonal antibody. Positive IHC detected in human lymphoma tissue. Positive WB detected in Recombinant protein.
-
Tested applications
ELISA, IHC, WB
-
Species reactivity
Human; other species not tested.
-
Alternative names
ALK antibody; ALK tyrosine kinase receptor antibody; ALK antibody; CD246 antibody; Anaplastic lymphoma kinase antibody; CD246 antibody; TFG/ALK antibody
- Immunogen
-
Isotype
Mouse IgG2a
-
Preparation
This antibody was obtained by immunization of ALK,CD246 recombinant protein (Accession Number: NM_004304). Purification method: Protein A purified.
-
Clonality
Monoclonal
-
Formulation
PBS with 0.02% sodium azide and 50% glycerol pH 7.3.
-
Storage instructions
Store at -20℃. DO NOT ALIQUOT
-
Applications
Recommended Dilution:
WB: 1:500-1:5000
IHC: 1:20-1:200
-
Validations

Immunohistochemistry of paraffin-embedded human lymphoma slide using (ALK,CD246 Antibody) at dilution of 1:50
Immunohistochemistry of paraffin-embedded human lymphoma slide using (ALK,CD246 Antibody) at dilution of 1:50

Recombinant protein were subjected to SDS PAGE followed by western blot with Catalog No:107572(ALK,CD246 Antibody) at dilution of 1:1000
-
Background
ALK, also named as CD246, is a receptor tyrosine kinase (RTK) that belongs to the protein kinase superfamily. ALK is usually found in the nervous system and appears to play an important role in the normal development and function of the nervous system. ALK was originally identified as part of the NPM (Nucleophosmin)-ALK oncogenic fusion protein, resulting from the (2;5)(p23;q35) translocation that is frequently associated with anaplastic large-cell lymphoma (ALCL). The EML4 (echinoderm microtubule-associated protein-like 4)-ALK fusion protein have been described in non-small-cell lung cancer (NSCLC), this transforming fusion kinase is a promising candidate for a therapeutic target as well as for a diagnostic molecular marker in NSCLC (PMID: 17625570).
Related Products / Services
Please note: All products are "FOR RESEARCH USE ONLY AND ARE NOT INTENDED FOR DIAGNOSTIC OR THERAPEUTIC USE"
